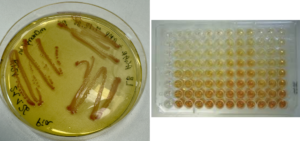

Anti-Virulence Drug Discovery Group
Leaders
What do we do?
Bacterial resistance is a rapidly growing global challenge. Instead of simply trying to kill bacteria, our approach is: Why kill them when you can disarm them?
We focus on identifying and designing novel compounds that target bacterial pathogenicity rather than viability—aiming to neutralize their ability to cause disease. Our research integrates computational and experimental approaches to:
- Explore the fundamental biology of bacterial metabolism and virulence during infections
- Validate novel targets involved in bacterial virulence, metabolism, and growth
- Perform biochemical and structural characterization of proteins using crystallography and cryo-EM
- Screen novel compounds using computational approaches
- Experimentally evaluate compounds through biochemical assays and phenotypic screening
Our ultimate goal is to discover new antibacterial compounds that can outsmart resistance mechanisms.
We specialize in molecular modelling techniques, including docking and virtual screening, QSAR model development, and molecular dynamics (MD) simulations.
We welcome collaborations with groups interested in using computational approaches to screen large chemical libraries against bacterial targets and to study protein–small molecule interactions.
We are a newly established research group seeking researchers who can contribute to experimental microbiology and screening.
If you are considering a Master’s Thesis Project or planning a PhD on any of the areas listed below:
- Infectious diseases (caused by bacteria)
- Antibiotic resistance
- Molecular Modelling
- Experimental Microbiology
please get in touch-we would be happy to discuss opportunities.
contact: [email protected]
-

We study bacterial proteins to understand their structure and function using X-ray crystallography and cryo-EM, including protein overexpression, production, and purification.
-

We utilize various computational approaches related drug discovery.
-
We perform experimental bioassays, including enzymatic assays and in vitro screening, to identify novel antibacterials targeting bacterial virulence and biofilms.
Keywords
Leaders
Doctoral Researchers
Other group members
-
Abiola Abdulkareem

